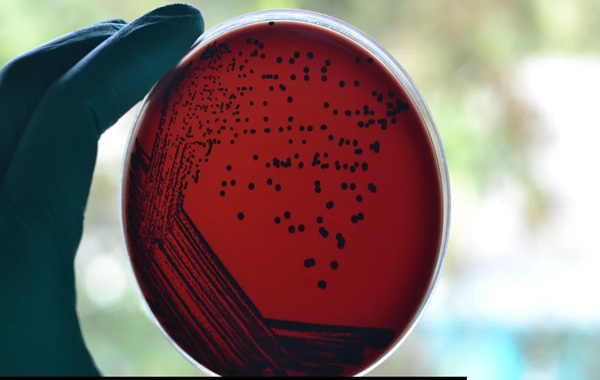
İnsan Vücudu İçinde

İnsan Vücudu İçinde Yeni Keşfedilen 35 Bakteri Türü
İsviçre’deki Basel Üniversite Hastanesi’nde hasta örneklerinde 30’dan fazla yeni bakteri türü keşfedildi. Bunlardan bazıları klinik açıdan önemlidir ve bu nedenle ilgili enfeksiyonları daha iyi anlamak veya tedavi bulmak isteyenler için yeni araştırma yolları açabilir.
Bulgular aynı zamanda henüz tanımlanmamış ne kadar çok patojen olduğunun da altını çiziyor – türümüzün başına bela olan bakteriyel enfeksiyonların zenginliğiyle mücadele etmek için ele alınması gereken bir konu. Bu koşullara neyin neden olduğunu bilmek, tedavilerini çok daha kolay hale getirmektedir; işte bu nedenle bu son çalışma gibi çalışmalar çok önemlidir.
Araştırmanın başyazarı Dr. Daniel Goldenberger yaptığı açıklamada, “Yeni tanımlanan bakteri türleri ile bunların klinik önemi arasındaki bu tür doğrudan bağlantılar geçmişte nadiren yayınlanmıştır” dedi.
Goldenberger ve ortak yazarlar 2014 yılından bu yana hasta örneklerini toplayıp analiz ederek, çeşitli tıbbi rahatsızlıkları olan kişilerden toplam 61 bilinmeyen bakteriyel patojeni inceliyor. Ancak bu bakteriyel genomları dizilemek zorlu bir iş oldu: geleneksel yöntemler sonuç vermeyince ekip analiz için nispeten yeni bir yönteme başvurmak zorunda kaldı.
Daha sonra dizileri bilinen türlerle karşılaştırmak için bir algoritma kullandılar ve 35 yeni tür belirlediler. Bunlardan 27’si derin doku örneklerinden veya kan kültürlerinden izole edildi ve en önemlisi, yedisi klinik açıdan önemliydi, yani insanlarda enfeksiyonlara neden olabiliyorlardı. Kalan 26 bakteri ise “tanımlanması zor” olarak sınıflandırıldı.
Yeni tanımlanan türlerin çoğu iki cinse aitti: Corynebacterium (altı tür) ve Schaalia (beş tür).
“Bu iki cinsteki birçok tür doğal insan deri mikrobiyomunda ve mukozasında bulunur. Bu nedenle sıklıkla hafife alınırlar ve haklarında yapılan araştırmalar seyrektir,” diye ekliyor Goldenberger. Ancak kan dolaşımına girmeleri halinde sağlığımız için tehdit oluşturabilirler.
Ekiplerin ilgisini çeken sadece yeni keşfedilen türler değil. Araştırmacılar, bir hastanın başparmağındaki köpek ısırığı yarasında bulunan “tanımlanması zor” bakterilerden birinin “yeni ve gelişmekte olan bir patojen” olduğunu varsayıyor. İlk olarak 2022 yılında Kanadalı bir grup tarafından köpek ve kedi ısırıklarının neden olduğu yaralardan izole edilmiştir.
Elde ettikleri başarılara rağmen, Basel Üniversite Hastanesi’ndeki hastalardan bilinmeyen patojenleri toplamaya ve dizilemeye devam eden ekiplerin çalışmaları devam etmektedir. Aslında, 20’den fazla yeni tür daha şimdiden listelerine eklenmiştir – bu türlerin gelecekte enfeksiyonların teşhis ve tedavisini iyileştirmeye yardımcı olacağı umulmaktadır.
Çalışmanın yazarları sonuç bölümünde “Kamuya açık klinik ve genomik veriler [bakteriyel organizmaların] klinik ve ekolojik rolünün daha iyi anlaşılmasına yardımcı olabilir” diye yazıyor. “Yedisi klinik açıdan önemli görünen 35 yeni suşu tanımlamamız, henüz tanımlanmamış patojenlerin ne kadar geniş bir yelpazede yer aldığını göstermektedir.”
Kaynak: https://www.iflscience.com
Derleyen: Figen Berber
Zaman Yolcusu Kadim Patojenler Dünyadaki Mevcut Bakterileri Yok Edebilir